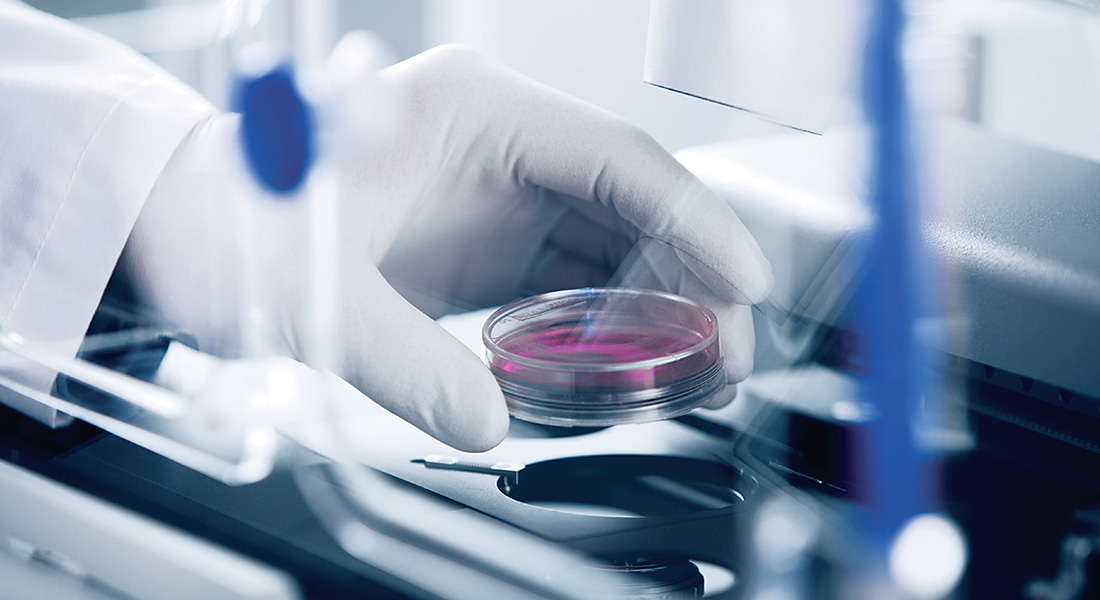
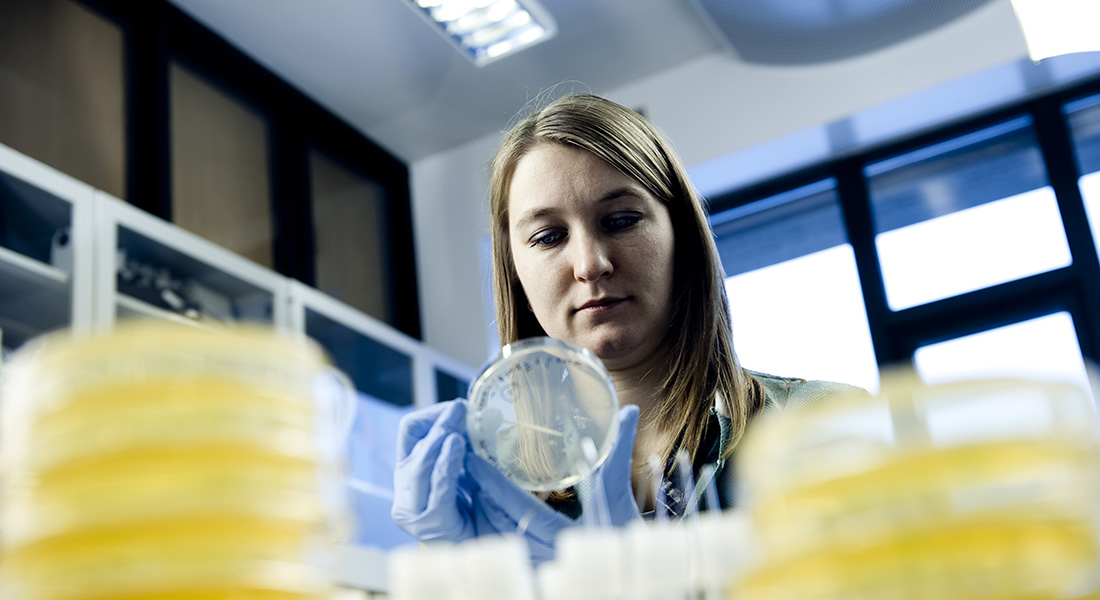

Head of Division
Signe Sørensen Torekov
Professor
Research Divisions
The Department's research is translational and placed in the cross-field between basic health research and the clinic/industry. The aim of our research is to generate new knowledge that can be used in the prevention and treatment of diseases, for example diabetes, cardiovascular disease, obesity, and cancer.
The research is conducted in Research Divisions.